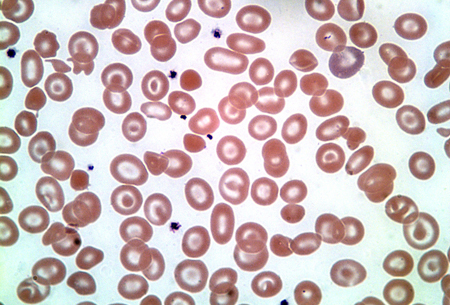

Resumo
Definição
História e exame físico
Principais fatores diagnósticos
- presença de fatores de risco
- sintomas de anemia
- esplenomegalia
Outros fatores diagnósticos
- infância ou início da vida adulta
- história familiar de talassemia alfa
- sintomas de cálculos biliares
- retardo de crescimento
- história prévia de suplementação de ferro
- icterícia
- aspectos faciais dismórficos leves
- hematopoese extramedular
Fatores de risco
- etnia de uma região geográfica com incidência de malária
- história familiar positiva
Investigações diagnósticas
Primeiras investigações a serem solicitadas
- hemoglobina (Hb)
- volume corpuscular médio (VCM)
- hemoglobina corpuscular média (HCM)
- contagem de eritrócitos
- esfregaço de sangue periférico
- percentual de reticulócitos
- ferro sérico
- ferritina sérica
Investigações a serem consideradas
- coloração de azul de cresil brilhante dos eritrócitos
- eletroforese de Hb
- fracionamento da Hb por cromatografia líquida de alta eficiência (HPLC)
- reação em cadeia da polimerase (gap-PCR)
- amplificação de múltiplas sondas dependentes de ligação
- sequenciamento direto/dot-blot reverso
- ressonância nuclear magnética (RNM) (hepática ou cardíaca)
- dispositivos supercondutores de interferência quântica (SQUID)
- biópsia hepática
Algoritmo de tratamento
Colaboradores
Autores
Janet L. Kwiatkowski, MD, MSCE
Director
Thalassemia Program
Children’s Hospital of Philadelphia
Professor of Pediatrics
Perelman School of Medicine
University of Pennsylvania
Philadelphia
PA
Declarações
JLK has participated in research trials of gene therapy sponsored by bluebird bio, Sangamo, Vertex, and Editas, and has participated in studies of pyruvate kinase activators sponsored by Agios and Forma Therapeutics. She has consulted for Agios, Forma, NovoNordisk, Chiesi, Biomarin, Regeneron, Vertex, and Bristol Myers Squibb (Celgene).
Agradecimentos
Dr Janet L. Kwiatkowski would like to gratefully acknowledge Dr Elizabeth A. Price and Dr Stanley L. Schrier, the previous contributors to this topic.
Declarações
EAP declares that she has no competing interests. SLS has received US National Institutes of Health (NIH) research funds, has received funds for organising an educational symposium, and is an author of a number of references cited in this topic.
Revisores
David H. K. Chui, MD, FRCPC
Professor of Medicine
Boston University School of Medicine
Boston
MA
Declarações
DHKC is an author of a number of references cited in this topic. He has received research grants or salary from the US National Institutes of Health greater than 6 figures USD.
Piero Giordano, PhD
Professor of Clinical Biochemical Molecular Genetics
Human and Clinical Genetics Department
Leiden University Medical Center
Leiden
The Netherlands
Declarações
PG declares that he has no competing interests.
Cornelis Harteveld, PhD
Clinical Molecular and Biochemical Geneticist
Department of Clinical Genetics
Leiden University Medical Center
Leiden
The Netherlands
Declarações
CH declares that he has no competing interests.
Créditos aos pareceristas
Os tópicos do BMJ Best Practice são constantemente atualizados, seguindo os desenvolvimentos das evidências e das diretrizes. Os pareceristas aqui listados revisaram o conteúdo pelo menos uma vez durante a história do tópico.
Declarações
As afiliações e declarações dos pareceristas referem--se ao momento da revisão.
Referências
Principais artigos
Thalassaemia International Federation. Guidelines for the management of alpha-thalassaemia (2023). 2023 [internet publication].Texto completo
Northern California Comprehensive Thalassemia Center. Standards of care guidelines for thalassemia. 2012 [internet publication].Texto completo
Artigos de referência
Uma lista completa das fontes referenciadas neste tópico está disponível aqui.
O uso deste conteúdo está sujeito ao nosso aviso legal